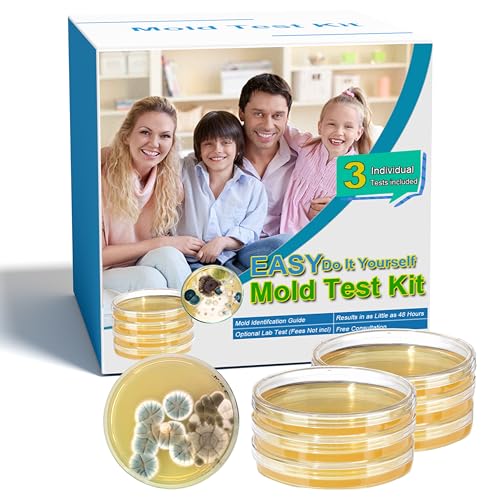
Mold Test Kit for Home- DIY Mold Detector for Home, 3 at Home Mold Air Test Kits - Test HVAC? Home Surfaces?Indoor Air Quality, Easy Black Mold Testing Kit Includes Detailed Mold Identification Guide

Product Information
Specification
Brand : Generic
BulletPoint : The Tell-Tale is fixed across the crack using screws and plugs and/or adhesive Fix the Tell-Tale over the crack with the vertical 0 line on the calibration scale parallel with the crack to be monitored. Ensure the plate with the engraved AVONGARD name is on the right hand side of the crack. Remove the two pre-set pegs. If the crack opens or closes the cursor moves relative to the calibration scale. The opening or closing of the crack can then be recorded on the record sheet.
BulletPoint1 : Complete Mold Test Kit for Home: Contains 3 agar plates, enough cotton swabs, plastic bags, test gloves, label paper, detailed mold identification and removal guide, free mold analysis service. The mold detector for home can comprehensively test the mold in your home, accurately locate the type of mold, and provide you with accurate and reliable results to protect the health of you and your family!
BulletPoint2 : Versatile At Home Mold Air Test Kit: Mold test kit for home air quality, home surfaces, and HVAC systems, providing a comprehensive monitoring of the living environment with these three testing methods. Effectively detecting bedrooms, bathrooms, kitchens, attics, basements, cars, and HVAC areas where mold may be hidden, our home mold test kit ensures a comprehensive mold assessment for any area of concern.
BulletPoint3 : 48-Hour Visible Mold Test Kit: The black mold testing kit for home provides a convenient detection process. According to the correct use method, accurate and reliable experimental results can be obtained in as fast as 48 hours. Mold growth requires a suitable temperature. If the temperature is below 77 ℉, the sample needs to be incubated for more than 48 hours, so please be patient.
BulletPoint4 : Safe And Easy To Use: Our at home mold test kit is specially designed for safety and convenience, and is your best choice for detecting mold at home. You can safely lead your children to conduct DIY tests and fun experiments at home to cultivate their hands-on ability. Trust our mold test kit to keep your health free from mold troubles.
BulletPoint5 : Mold Identification Guide, Free Professional 24/7 Analysis: We provide a detailed mold guide and removal manual. Compare the test results with the pictures in the guide to quickly identify the mold in your home and effectively remove it. If you can't identify it, please send us a picture of the mold and the professional staff of the laboratory will answer your questions 24/7.
Color : Black
ExternallyAssignedProductIdentifier1 : 663566012810
ExternallyAssignedProductIdentifier2 : 0663566012810
IncludedComponents : 3 Test Plates, Identification Guide, Instructions Manual
IncludedComponents1 : bolts
IncludedComponents2 : wrench
ItemDisplayDimensions_Length : 3.54 centimeters
ItemDisplayWeight : 0.86 pounds
ItemName : Mold Test Kit for Home- DIY Mold Detector for Home, 3 at Home Mold Air Test Kits - Test HVAC、 Home Surfaces、Indoor Air Quality, Easy Black Mold Testing Kit Includes Detailed Mold Identification Guide
ItemPackageDimensions_Height : 11.9888 centimeters
ItemPackageDimensions_Length : 6.1976 centimeters
ItemPackageDimensions_Width : 11.303 centimeters
ItemPackageQuantity : 1
ItemTypeKeyword : calibration-surface-plates
ItemVolume : 1 cubic_centimeters
Manufacturer : Ruichu
Material : hardened steel
Material1 : Stone
Material2 : granite
MeasurementAccuracy : 100% Accuracy Rate
ModelNumber : 2520-1000
NumberOfBoxes : 1
NumberOfItems : 3
NumberOfLithiumMetalCells : 1
PartNumber : RIV001
PowerSourceType : electric
ProductDescription : Take control of your indoor air quality with this comprehensive DIY mold test kit. The kit includes three separate detection tests to help you identify potential mold issues in different areas of your home. Perfect for homeowners, landlords, and property managers who want to assess indoor environments, this testing kit comes with a detailed identification guide to help interpret your results. The easy-to-use tests can help detect the presence of mold in your living spaces, basement, bathroom, or any area of concern. Whether you're conducting preventive checks or investigating suspicious spots, this kit provides the tools needed for preliminary mold detection. The included guide walks you through the testing process step by step, making it straightforward to collect samples and understand the findings. Keep in mind that while this kit offers initial screening, professional inspection may be needed for comprehensive assessment.
ProductSiteLaunchDate : 2025-05-09T06:21:15.308Z
Size : 3 pack
SupplierDeclaredDgHzRegulation : not_applicable
SupplierDeclaredHasProductIdentifierExemption : 1
UnitCount : 1
UnspscCode : 52150000